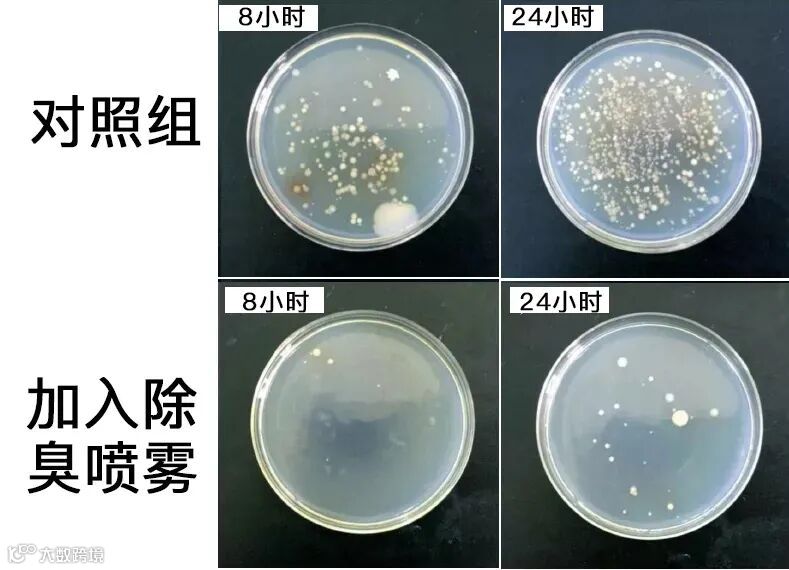

一到夏天,就属蚊子最敬业了!
专挑睡觉时间,在你耳边嗡嗡嗡吹喇叭!开灯就消失,关灯就被咬!想睡个安稳觉?没门!

就算你住在20楼,蚊子都能飞上来,送你一连串的“大红包”!又红又痒,挠破皮都不过瘾!
胳膊、大腿、脸上全是脓包、黑疤,美美的短裙也只能压箱底...太气人了!

更可怕的是,蚊子还会传播疟疾、黄热病等80多种疾病,每年有70多万人因它而死亡!

最最恐怖的就是西尼罗河病毒!平均每4人中就有1人死亡!死亡率远高于新冠肺炎!

请你想象一下,刚刚叮过马桶、爬过垃圾堆的蚊子,啃食你的面包,溜进你的水杯,再把那根携带着10万病毒的针,深深扎进宝宝娇嫩的皮肤...后果不堪设想!

为了治治蚊子这个烦人精,我们也是拼了!
蚊香、电蚊香味道刺鼻,还含有DDT等致癌物,一卷蚊香的毒性=75支香烟!太可怕!
灭蚊灯呢?光线刺眼、声音吵,自己睡不好觉是肯定的,还超级贵!

而且就算把蚊子赶跑了,身上的蚊子包还是一堆又一堆,爱美的姐妹可受不了啊!
宝宝肌肤娇嫩就更不用说了,抓挠留下的黑疤,好几个月都下不去,太影响颜值啦!

别着急,小编今天给你推荐净笙集艾叶柠檬驱蚊喷雾(简称绿宝瓶)
出门喷一喷,蚊子掉头就跑!睡前一喷,自带隐形防蚊罩,驱蚊8小时,窗户大开都没蚊子,一觉睡到大天亮!太爽了!

由河南中医药大学20多位博士专家研发,国家专利产品,主打“蚊虫克星”天然艾叶精油,还有淡淡植物香氛!
因为是植物温和配方,不含化学驱蚊成分,小编家有孩子,用起来也很放心!

更惊喜的是,别看它名字叫驱蚊喷雾,其实人家止痒消肿、去蚊子印的实力也无人能敌!

小编我是疤痕体质,被蚊子亲一口,鼓出硬币大的肿块,捂到冬天都还有黑印,丑哭了!
现在只要用绿宝瓶喷一喷,蚊子包立马消停不痒了,也不会留黑疤哦!

一上线就爆卖10万瓶,多次霸屏小红书首页精选,朋友圈也抢到脱销,堪称“驱蚊神水”“蚊不叮”,口碑好到炸!


消掉蚊子包
喷一次,一天都不痒
你知道吗?被蚊子咬一口,毒液会像打吊针一样,透进皮肤里,让你痒痒痒没商量!
所以呢,要想真正摆脱瘙痒,灭掉蚊子包上的细菌毒液是关键!

而市面上的驱蚊喷雾,压根没有止痒消肿效果!
止痒喷雾、止痒液呢?对细菌无能为力!主要靠薄荷来清凉皮肤,但2分钟后清凉感散去,瘙痒又袭来了!

而绿宝瓶就牛逼多啦!
特别添加“细菌杀手”石菖蒲、“肌肤卫士”广藿香这对止痒消肿界的黄金cp,将蚊子包上的细菌一网打尽!真正止痒消肿!

杀菌力有多强?我们眼见为实!
在蚊子包上蘸取一点病菌涂在2个培养皿上,8小时后,对照组已被细菌占领;
而喷了绿宝瓶的培养皿,24小时后也只有零星几个细菌,喷一次管用一整天!效果太赞了!
就连以严格著称的科高检测机构,也给出了权威结果,对大肠杆菌、金黄色葡萄球菌抑制率高达99.8%!
河南科中科学院重点实验室、中美联合实验室。它的认可,足以证明绿宝瓶的效果超棒、安全靠谱!

绿宝瓶滋滋滋一喷,你猜怎么着?凉丝丝的,像冰块在手上化开。刺痛灼热感也被带走了!
10分钟后发红的肿块消退了一大半,没有了抓挠的冲动,一整天都不痒了!

更惊喜的是,它还特别从柠檬之乡--四川安岳柠檬中提取出美白嫩肤因子!

快速渗透皮肤,哒哒哒地分解蚊子包黑色素,满腿满身的蚊子疤、黑印也能轻松去除,分分钟白嫩起来。

买家@大美林:
闺蜜推荐它时,我是怀疑的:驱蚊喷雾能蚊子印?但死马当活马医,试试吧!
没想到用了一瓶,黑疤居然真的淡了很多!腿还白了2个度,天生黑黄皮的我,也能逆袭成大白腿呢!

买家@ 一只兔子:
一到夏天,蚊子准会叮上我这块“唐僧肉”!手臂上的黑疤一年都消不掉!
一瓶还没用完,黑印子一个不留地全给去掉了!这下短袖、吊带随心穿,开心到飞起!

买家@ 雯雯:
别的小姐姐腿又白又嫩,可我一到夏天腿上全是蚊子包,丑的我根本不敢露腿!
今年有了绿宝瓶,不但没蚊子了,连腿上的黑印也没了。终于可以美美地穿上短裙短裤啦!

一喷驱蚊8小时
开窗睡觉都没蚊子
绿宝瓶说到底还是一瓶驱蚊喷雾,驱蚊效果自然也是相当优秀了!
你可以看到,左手蚊子密密麻麻;而喷了绿宝瓶的右边手臂,一只蚊子都没有!

而且为了说明效果,研究人员特意选的最毒、最有攻击性的白纹伊蚊。
你想啊,就连蚊子界的老大哥都“全军覆灭”,普通蚊子就更不在话下了,对吧!

为啥它驱蚊效果如此强大?秘密就是核心成分:艾草精油--植物驱蚊界一等一的高手。
你知道吗?每年夏天,全国各地蚊虫大爆发,唯独背靠艾叶林的小乡村,没有蚊虫困扰!

研究走访才发现,当地人从不用蚊香,每家每户都习惯把艾叶挂在门上驱蚊。
这是因为,艾草释放出的治愈清香,我们闻着喜欢,但蚊子一闻到,像被打了一针强效麻药,神经中枢立马失效,10秒就倒地。

研发师陈本宁博士告诉我们:全国艾草有300多种,但公认驱蚊效果zui好的来自中国艾都--河南南阳。
280公斤艾草和32小时机器工作,才能萃取出一升艾草精油。价格高达千元,是名副其实的驱蚊界“液体黄金”。

从中提取出的艾草精华,驱蚊效果比普通艾草强8.5倍!
有它保护,再胆大包天的蚊子也不敢靠近你!

买家@ 蓝蓝:
半夜起来打蚊子太折磨人,还被叮到满脸包!有了绿宝瓶后,身上一喷,蚊子大部队集体撤退,再也听不到嗡嗡嗡了。
家里、车里也用它。出差、上班、买菜,包里一揣就出门,特方便!

买家@ 晓静:
家有俩娃都是招蚊体质,我这当妈的真的心碎。幸好宝妈群里推荐了它,效果太赞!
带娃去散步、游乐场、山里露营,身上也没带回一个蚊子包!太牛了!而且是植物、大牌子很放心!
淡淡植物香氛
老人小孩都能放心用
大部分驱蚊喷雾、电蚊香都有一个通病:浓浓的化学刺鼻味,一闻就想打喷嚏。
为了克服这一难题,研发团队耗时200天、876次调试,终于研制出植物香氛黄金配比!

初闻是艾叶清香,喷在手臂上,凑上鼻尖一闻,是一股柠檬的清爽感。
过2分钟,柠檬包裹着淡雅的花香闯入鼻尖,像走进了春日花园,3分浪漫,3分清新。
香味超治愈,吊打普通花露水、驱蚊喷雾!

植物草本配方,0重金属0避蚊胺等化学驱蚊成分,温和无刺激,老人孩子放心用哦!
全身可用!如果是脸部驱蚊和止痒,先喷在手心,再点涂就可以啦,丝毫不辣眼睛!

研发团队尽是医学博士、专家等行业大咖,专注草本植物研究,尤其是对草本驱蚊、养肤的运用,论专业程度,没人比他们更专业!

生产厂家伊莱恩生物科技来头更大,是国内首屈一指的研发机构!
像美肤宝、上海家化、自然堂、植观、相宜本草等口碑响当当的大品牌,都是它合作出品的呢!

每一瓶喷雾,全程在欧美GMPC标准、10万级无菌净化空间生产,严格控制品质!
一上市就从89个对手中脱颖而出,斩获上百项权威认证!

效果惊艳,迅速刷爆小红书、朋友圈!
大家都是3-5瓶抱回家,5人中就有4人推荐给亲友同事。10万买家都抢着晒好评👍

性价比超高
送89元艾草驱蚊膏
普通电蚊香、驱蚊喷雾,多是避蚊胺、驱蚊酯等化学成分,效果差、味道刺鼻不安全。
就连某宝70多元的销冠产品,评论区也藏着几千条差评,朋友们要擦亮眼睛!

而绿宝瓶呢?天然植物配方,温和无刺激,驱蚊8小时,还能5秒止痒消肿、不留印!
闻起来也是淡淡植物香氛,超治愈!
价格更是惊喜到爆!日常69元/瓶,今年2代升级版新上线,限时6折只要39.9元/瓶,买2送1,买3送2!

送15ml便携喷瓶
绿宝瓶满满一瓶200ml,能喷600次!放着家里用正合适!
平时上班、旅行、出差呢,就用便携小喷瓶,才一根手指粗,再小的包包都放得下!

--净笙集艾叶柠檬驱蚊喷雾--
原价69元/瓶
粉丝6折福利:39.9元/瓶
买2送1
买3送2
家里、办公室一瓶,给自己、给父母一瓶。
5瓶也才100多,给你和家人多重保护!这么实惠有效,还有什么理由拒绝呢?

【买2送1 买3送2】夏夜无蚊虫叮咬 安心睡眠一整夜 天然防蚊 长效驱蚊 贴身呵护 避呅亭喷雾








